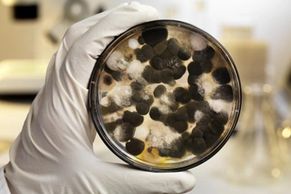
Mold Testing, ECO Mold Testing, Mold Removal, Testing for Mold, Indoor Air Quality, Inside Mold Test

Signed in as:
filler@godaddy.com

Teams are ready to assist with any size sanitizing and disinfecting job. Serving all of SW Florida. While it is important to mention that disinfecting and sanitizing service is not guaranteed to protect you from the Coronavirus, our experts have the training and technology to help reduce the risk of infection on a range of properties. Let Precision Mold Restoration help keep your Florida home or business safe.
If you are concerned about the impact of the Coronavirus on your commercial or residential property in Florida, reach out to Precision Mold Restoration today at (239) 900-3459. We provide free, in-person inspections and estimates.
It's quite possible that mold damage may occur within 24-48 hours if surrounding structures are not properly dried. Upon request, we can provide you with a State licensed 3rd party testing company for both the pre and post mold verification.
Mold testing must be performed by a 3rd party company in order to prevent conflict of interest. This will apply for pre and post mold testing to include any building restoration service you may have.
It's essential not to make the same mistake that many Florida homeowners do and believe that mold is harmless or even nonexistent simply because it cannot be seen with the naked eye.
Once the pre test report is complete, our certified technicians then assess the mold report, quickly survey the damage that may have occurred and address the affected area by having it ready for post test verification. Our main office is in Cape Coral, Florida, but we can test and service any property in South Florida.
When this happens to your home, call Precision Mold Restoration.

Precision Mold Restoration should be your first call for mold removal in Southwest Florida. We provide service in Lee, Collier, Sarasota, De Soto, Highlands, Glades, Hendry, Charlotte, Miami-Dade, Broward, Palm Beach, Martin, St. Lucie and Broward Counties. and we are licensed and insured for the entire State of Florida. Ask about our electrostatic disinfection services for preventative measures against mold and bacteria growth.

Under Florida mold law:
-The law of mold removal has changed in the past few years in order to prevent non-licensed companies from performing mold remediation services in Florida.
-Any mold related issue that involves removal of mold impacted material over 10 square feet must be performed by a state licensed remediation company to ensure cross contamination does not occur.
-For mold testing, you must use a Florida licensed 3rd party company in order to prevent conflict of interest. This will apply for pre and post mold testing services.

We Guarantee a passing post mold test result!
All work is done to meet or exceed not only code, but your expectations as well. The work performed will be on time, on budget and with the quality you expect... and deserve.
Precision Mold Restoration has industry leading mold remediation technicians to resolve your mold removal problem, leaving you with a healthier home, and help you ensure that your heightened humidity levels are no longer an issue. We are positioned to help point out any water/moisture points of access that will need fixed that may contribute to mold proliferation and any black mold issues. We also offer electrostatic disinfection for preventative measures.

Cleaning even a moderate area of mold will release high mold spore concentrations into the air when disturbed, which could have the possibility of making you feel sick. Heavy concentrations of mold spores could cause or worsen health problems. It is not a good idea to remove extensive areas of mold yourself. For example, if you suspect mold is growing between the walls of your home, behind the kitchen cabinetry/bathroom vanities or under different types of flooring- weather its light mold or black mold... call a pro for your mold removal needs!

Electrostatic Disinfection for New Home Construction-
Mold problems are not exclusive to older homes. Precision Mold Restoration LLC's mold removal and antimicrobial solution with electrostatic application in every new home you build. You will not only protect yourself from lawsuits, but increase profitability and offer a way to differentiate your building model and finished product from your competition.
The average cost of a mold lawsuit: builder $50K , homeowner $25K, settlement $150K.
In only two years, insurance paid nearly 4 billion dollars in mold claims.

Precision Mold Restoration has a history of completing high quality small and large restoration projects for customers in South West Florida from Collier County to Charlotte County including homeowners and businesses.
As a licensed and insured business in mold restoration, we provide restoration services for both commercial and residential properties. Our highly trained team of professionals has hands on experience with insurance-related property damage as well. We understand that responding to your emergency event is more than just restoring the damage. It’s bringing hope to a local resident that needs consolation after an unexpected loss at their home. It’s providing confidence to a business owner who is determined to minimize the downtime, for his/her business as well as his/her employees.
Our vast experience in this field allows us to understand insurance related issues and communicate well with the insurance adjuster and insurance agency.
After we meet with our client to assess the damage and prepare a free estimate, work can begin immediately to restore the loss, stabilize the current situation, and prevent any additional damage. We can even forward the detailed estimate to the insurance carrier for review and payment.
Precision Mold Restoration technicians are expertly trained and proficient in all aspects of mold restoration. Whether it’s a small or large property, we can guide our customers through the entire restoration process. You can count on Quality Service and Excellence with Precision Mold Restoration. For more information, call us today.

We offer an end-to-end client experience that includes seamless communication, budgeting, staffing, on-site organization, and solid, quality work every time.

We have worked with homeowners and insurance companies to produce top notch work. Call us today and bring our project management skills and extensive indoor air quality experience to your next project.
